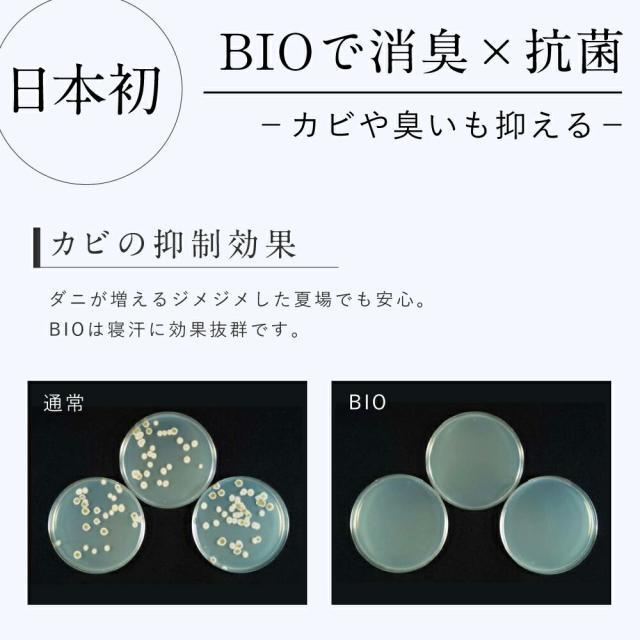

【楽天1位】【長崎県立大学と共同開発】 10枚 ダニランドリー ダニ捕りシート ダニ取りシート ダニとりシート ダニシート 防ダニ ダニ 対策 駆除 退治 掃除 部屋 敷布団 掛布団 布団 枕 カバー シーツ マット マットレス パッド カーペット ベビー 貼る 日本製
(100件)
メーカー希望小売価格: 4,000円
1,599円(税込)
0ポイント(1%)
商品説明

【 特許出願中 BIO成分 】
日本で初めて「ダニの誘引だけではなく、
カビの"抑制抗菌"&"消臭効果"を発揮する」
BIO誘引剤を開発しました。
【 買ってよかった!!貼るタイプ 】
暗闇を好むダニは布団の表側ではなく、
実は"裏側"に潜り込んでいます!
当商品は裏側にペタッと貼れるので
"効率的に誘い出し捕獲"できます。
【 まさに"ダニの洗濯機" 】
(1)BIOの香りでダニを効果的に誘引
(2)乾燥剤(シリカゲル)でダニを脱水・死滅
(3)ダニの死骸を残さない防アレルギー
※殺虫剤は不使用。
【 BIOはココが違う! 】
ダニを誘引するための食品添加物(香料)は
誘引効果が十分に見られないだけでなく、
ダニの餌となり"繁殖の原因"にもなります。
そこで、当店では"繁殖の原因"とならない
BIO誘引剤を開発しました。
【 大容量 10枚入り 】
■使用目安3ヶ月
■設置目安1枚1〜1.5畳
シングルベッドで2枚
ダブルベッドで4枚
※ダニの歩く速度は遅いので即効性はありません。
日本で初めて「ダニの誘引だけではなく、
カビの"抑制抗菌"&"消臭効果"を発揮する」
BIO誘引剤を開発しました。
【 買ってよかった!!貼るタイプ 】
暗闇を好むダニは布団の表側ではなく、
実は"裏側"に潜り込んでいます!
当商品は裏側にペタッと貼れるので
"効率的に誘い出し捕獲"できます。
【 まさに"ダニの洗濯機" 】
(1)BIOの香りでダニを効果的に誘引
(2)乾燥剤(シリカゲル)でダニを脱水・死滅
(3)ダニの死骸を残さない防アレルギー
※殺虫剤は不使用。
【 BIOはココが違う! 】
ダニを誘引するための食品添加物(香料)は
誘引効果が十分に見られないだけでなく、
ダニの餌となり"繁殖の原因"にもなります。
そこで、当店では"繁殖の原因"とならない
BIO誘引剤を開発しました。
【 大容量 10枚入り 】
■使用目安3ヶ月
■設置目安1枚1〜1.5畳
シングルベッドで2枚
ダブルベッドで4枚
※ダニの歩く速度は遅いので即効性はありません。
レビュー
- 初めて購入しました。
- 効果があれば定期的に購入したいと思います。早い対応ありがとうございました。
- 早速使ってみます
- 商品が届くのが早い。ありがとうございます。早速使ってみます。
- 小さめ
- 今回は違うダニシートを買いました。前回のより小さめです 効果があるといいかな
- 早速
- 猫がいるので、届いてすぐに使用しました。 以前違う商品を使用していましたが、今回はこちらの商品を購入してみました。目には見えないので効果はわかりませんが、リピしようかと思ってます。
- すぐに届きました
- 早速使いました。個包装で貼り付けても置くだけでも大丈夫なのがいいです!
すべてのレビューを見る
お店の情報
お店の評価:



 -点(0件)
-点(0件)
連絡・応対
-
配送スピード
-
梱包
-









